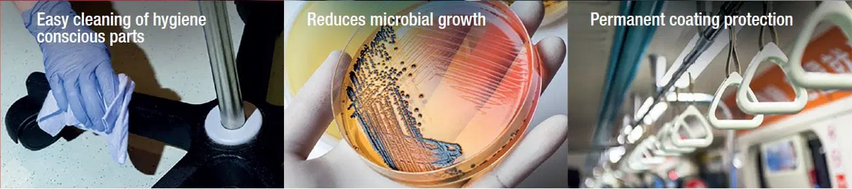

Company details for:
Curtiss-Wright Surface Technologies
Quick Links:
Products / Services

Controlled Shot Peening
Component failure is often related to residual tensile stress induced during manufacture and certain operating conditions. The controlled shot peening process is a cost effective and practical method of replacing tensile stress with beneficial compressive stress which is proven to prevent failures due to:
- Metal fatigue
- Corrosion fatigue
- Stress corrosion cracking
- Intergranular corrosion
- Fretting
- Galling
- Spalling
- Wear

Shot Peen Forming
Varying curvature requirements, material thickness, cut outs, reinforcements and pre-existing distortion can all be processed.

Laser Shock Peening
Laser peening is not a replacement for controlled shot peening, but has additional advantages that can influence which method to use.

C.A.S.E Isotropic Super Finishing

Thermal Plasma & HVOF Spray Coatings
Damaged and worn parts such as gas and steam turbines can be repaired to original specification.

Engineered Coating Services

Parylene Conformal Coatings

IMR Test Labs − Material Testing Services

Onsite Repair & Overhaul Services

Peentex Surface Texturing & Architectural Finishes
Controlled shot peening has long been associated with engineered surface finishing of metals including steels, stainless steels, aluminium, titanium and copper alloys. It forms an essential part of the manufacturing process used within the engineering industry to improve wear and corrosion resistance and prevent premature fatigue failures.

Peenflex Protective Moulding & Masking
Developed to protect components during our own processing we have now extended this service and produce mouldings directly for our customers.
Using our knowledge and experience, we are able to assess component requirements to produce mouldings to meet customers’ specific needs and reduce unnecessary costs resulting from damage, delays and rework.
All our mouldings are rigorously tested to ensure a high quality of wear resistance enabling them to be recycled many times through the handling stages, and presenting a cost effective solution to damage prevention.

AM (Additive Manufacturing Process)

Component Coating & Repair Services
Component Coating and Repair Services (“CCRS”) are specialists in coatings and repair services for both new manufacture and the overhaul of steam/gas turbine and aerospace components, services include overlay and diffused coatings, vacuum brazing and a full range of Ipcote coatings for protection against corrosion and erosion, anti-fouling and dry film lubrication.

Everlube® Coatings
Everlube® coatings are a range of tough coatings know as dry film lubricants that provide low frictional resistance between two mating parts.
Dry film lubricant coatings have different properties depending on their structure and composition. These properties can be for high load bearing, very low coefficient of friction, high temperature and also increased resistance to chemical attack, abrasion and corrosion.
The Everlube® coatings range includes environmentally friendly and REACH compliant coatings as well as air cured, high temperature and PTFE.
In addition to the Everlube® coatings range other leading product brands include Lube-Lok®, Lubri-Bond®, Ecoalube®, Ever-Slik®, Esnalube™, Perma-Slik®, Electrobond®, Formkote® and Henco-Mask™.
Fluregiene 200™ – Anti-Microbial Coating
Fluregiene 200 is a unique fluoropolymer coating which we provide as part of our engineered performance coating services. Our antimicrobial coating offers low friction combined with superb chemical and abrasion resistance. We launched Fluregiene 200™ back in February 2022, this antimicrobial coating is both flexible and formable and offers outstanding wear resistance properties.
About us
Curtiss-Wright Surface Technologies are global industry leaders in a range of specialist surface treatments for the following market sectors…
- Aerospace
- Chemical
- Commercial
- Heavy Automotive
- F1
- Healthcare
- Oil & Gas
- Mining
- Power Generation
- General Engineering
Curtiss-Wright’s services include Controlled Shot Peening, Shot Peen Forming, Laser Peening, C.A.S.E Isotropic Finishing Super Finishing, Thermal Spray Coatings, Engineered Coatings, Parylene Conformal Coatings, Wet Treatments (Adonising), Material Analysis and Testing, On-Site Services, Material Analysis and Testing, Peentex Architectural Finishes & Peenflex Protective Mouldings.
Our key aim is to improve the longevity, quality and performance of those all important components. From protecting aero-engine components from extreme heat and thermal variation to the protection of medical devices from corrosion and high load conditions.
We also have the facilities to treat airframes, wing skins and undercarriages of aeroplanes, storage tanks, pumps, pressure valves, crankshafts, cylinder heads, gears, connecting rods, race tracks, drill collars, pipes, storage vessels, steam & gas turbine components & much more. We are not limited in our ability to deal with a particular shape, size or complexity of a component. Tooling and equipment can be manufactured in-house if required.
With over 70 worldwide facilities and on-site field teams, we have a location within close reach of our customers for faster turnaround and reduced costs. Our dedicated teams will visit your site anywhere in the world at short notice to repair your fixed or large equipment.
Images





































